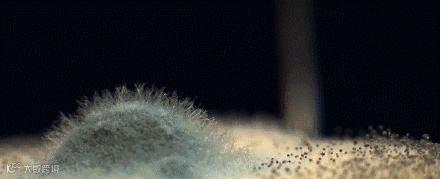

筷子,是我们几乎一日三餐都离不开餐具~
它不仅仅能把美味的食物送到我们的嘴边,也能成为细菌、病毒入侵我们身体的媒介!

潮湿、空气中的细菌、神出鬼没的小虫子,很容易令筷子藏污纳垢,时间一长便开始霉变。

一旦发霉,就会产生一级致癌物黄曲霉菌,诱发各种癌细胞的产生!!严重威胁到我们的健康~
你想想,用这样的筷子吃饭,每天得吃进去多少细菌啊……

所以说筷子真的不是你拿洗洁精洗一下、热水烫一下、钢丝球刷一下、晾干了就能用!
一个真实故事:
2018年某节目曝光:北京一位女士,2013年被检测出患有癌症。更可怕的是,她的爸爸、哥哥等一家四口全是相继患癌去世。
医生进行了大量的分析实验,发现了王女士家用的筷子上存在大量致癌细菌——黄曲霉菌!

越想越觉得消毒太有必要了,吃个饭都提心吊胆,总不能顿顿换筷子吧。

今天小编带来了一个餐具消毒好物——DGQ紫光智能筷子筒。
高速风干+紫光消毒+封闭储存三大模块,能从根本上杜绝筷子滋生细菌!让我们彻底告别“病从口入”~
【DGQ紫光智能筷子筒】
智能风干 / 紫光消毒 / 封闭储存 / 方便拿取
原价¥ 189 | 限时优惠¥129
▼

自2016年以来DGQ以科技守护健康为使命,坚信科技创新改变生活,获得众多荣誉~

很多朋友使用过后都纷纷给出好评:

-01-
紫光照射,杀菌祛味还速干
01.高速风干
潮湿,是造成筷子发霉的最主要原因~
相信很多家庭,清洗完筷子后一般都是“甩一甩”就直接放进筷子筒,潮湿的筷子加上密闭的环境,底部很容易滋生细菌、发霉。

而这款筷子筒,内置了转速为6000rpm的高速风干系统,不让霉菌存在任何滋生的机会。

刚清洗完的筷子和餐具不用特意去沥水,直接放进去,就可以被快速烘干,从根源上破坏了细菌生长的有利环境,治标又治本!

02.紫光杀菌
除了风干系统外,它还设计了紫光消毒系统。机器开启工作的同时,机器内两盏紫光灯也会自动开启,在筷子风干的过程中全程紫光照护!

通过紫外线强力杀菌,破坏细菌机体细胞分子结构,造成致死性损伤,杀除金黄色葡萄球菌、白色念珠菌、大肠杆菌……等多种常见细菌,使用更安心。

虽说家里有消毒柜,但每顿饭都打开消毒不太现实,而且使用率也不高,反正我家的是落灰了,有一个单独的筷子筒就方便很多。
03.封闭式储存
市面上80%的筷子筒都采用半封闭式的结构。
餐具通常有大半截裸露在空气中,很容易就会被小爬虫爬过,光想想就恶心~

DGQ紫光筷子筒的密封设计正能解决这个问题,除了防尘防蟑螂还能防止厨房的油烟产生的二次污染(厨房油烟的危害妈妈们都懂的!)

老人、宝宝免疫力比较差,有它帮助,拒绝病从口入,吃得更放心!
-02-
外观美观,安装便捷
01.侧开合设计
视野更清晰,一眼就能看到想要的,小孩都能轻松拿取。

轻轻一推,即开即合,拿取方便还不沾灰!

02.免打孔设计
强力粘贴,不管是小女生还是有经验的妈妈都能轻松就能贴到墙上,稳固不脱落!

背部是3M胶带,承重好,稳固不脱落~
常见的瓷砖、玻璃、光滑木材、大理石、金属表面、亚克力表面等,都可以牢牢贴住。

03.独立结构,可拆卸
拆洗起来也非常方便,筷筒是独立的结构的,能很方便地从墙面拆下进行清洗并完成沥水。
随时保持筷子及筷筒的双重清洁。

04.超大容量
小小一个,一次却最多能容纳40双筷子,刀叉勺也能放下不少,一个家庭用够够的了~
由DGQ实验室数据显示:独立放筷子约40双,勺子15个,叉子15个。

05.壁挂设计
最棒的是,壁挂式设计,想挂那里就挂那里,既好看又实用~

-03-
两种模式,每天仅需0.17元守护家人健康
开机默认自动模式,长按开关键3秒切换模式。

自动模式亮蓝灯;手动模式亮绿灯。

还有一个大家肯定非常关心的问题——电费。超人性化的节能筷筒,让你没有此类烦恼!
算上每天使用三次,一个月只需0.29度电,约0.17元!365天仅需3.48度电。

这么低成本就能守护家人健康, 难道不值吗?
【DGQ紫光智能筷子筒】
智能风干 / 紫光消毒 / 封闭储存 / 方便拿取
原价¥ 189 | 限时优惠¥129
▼






